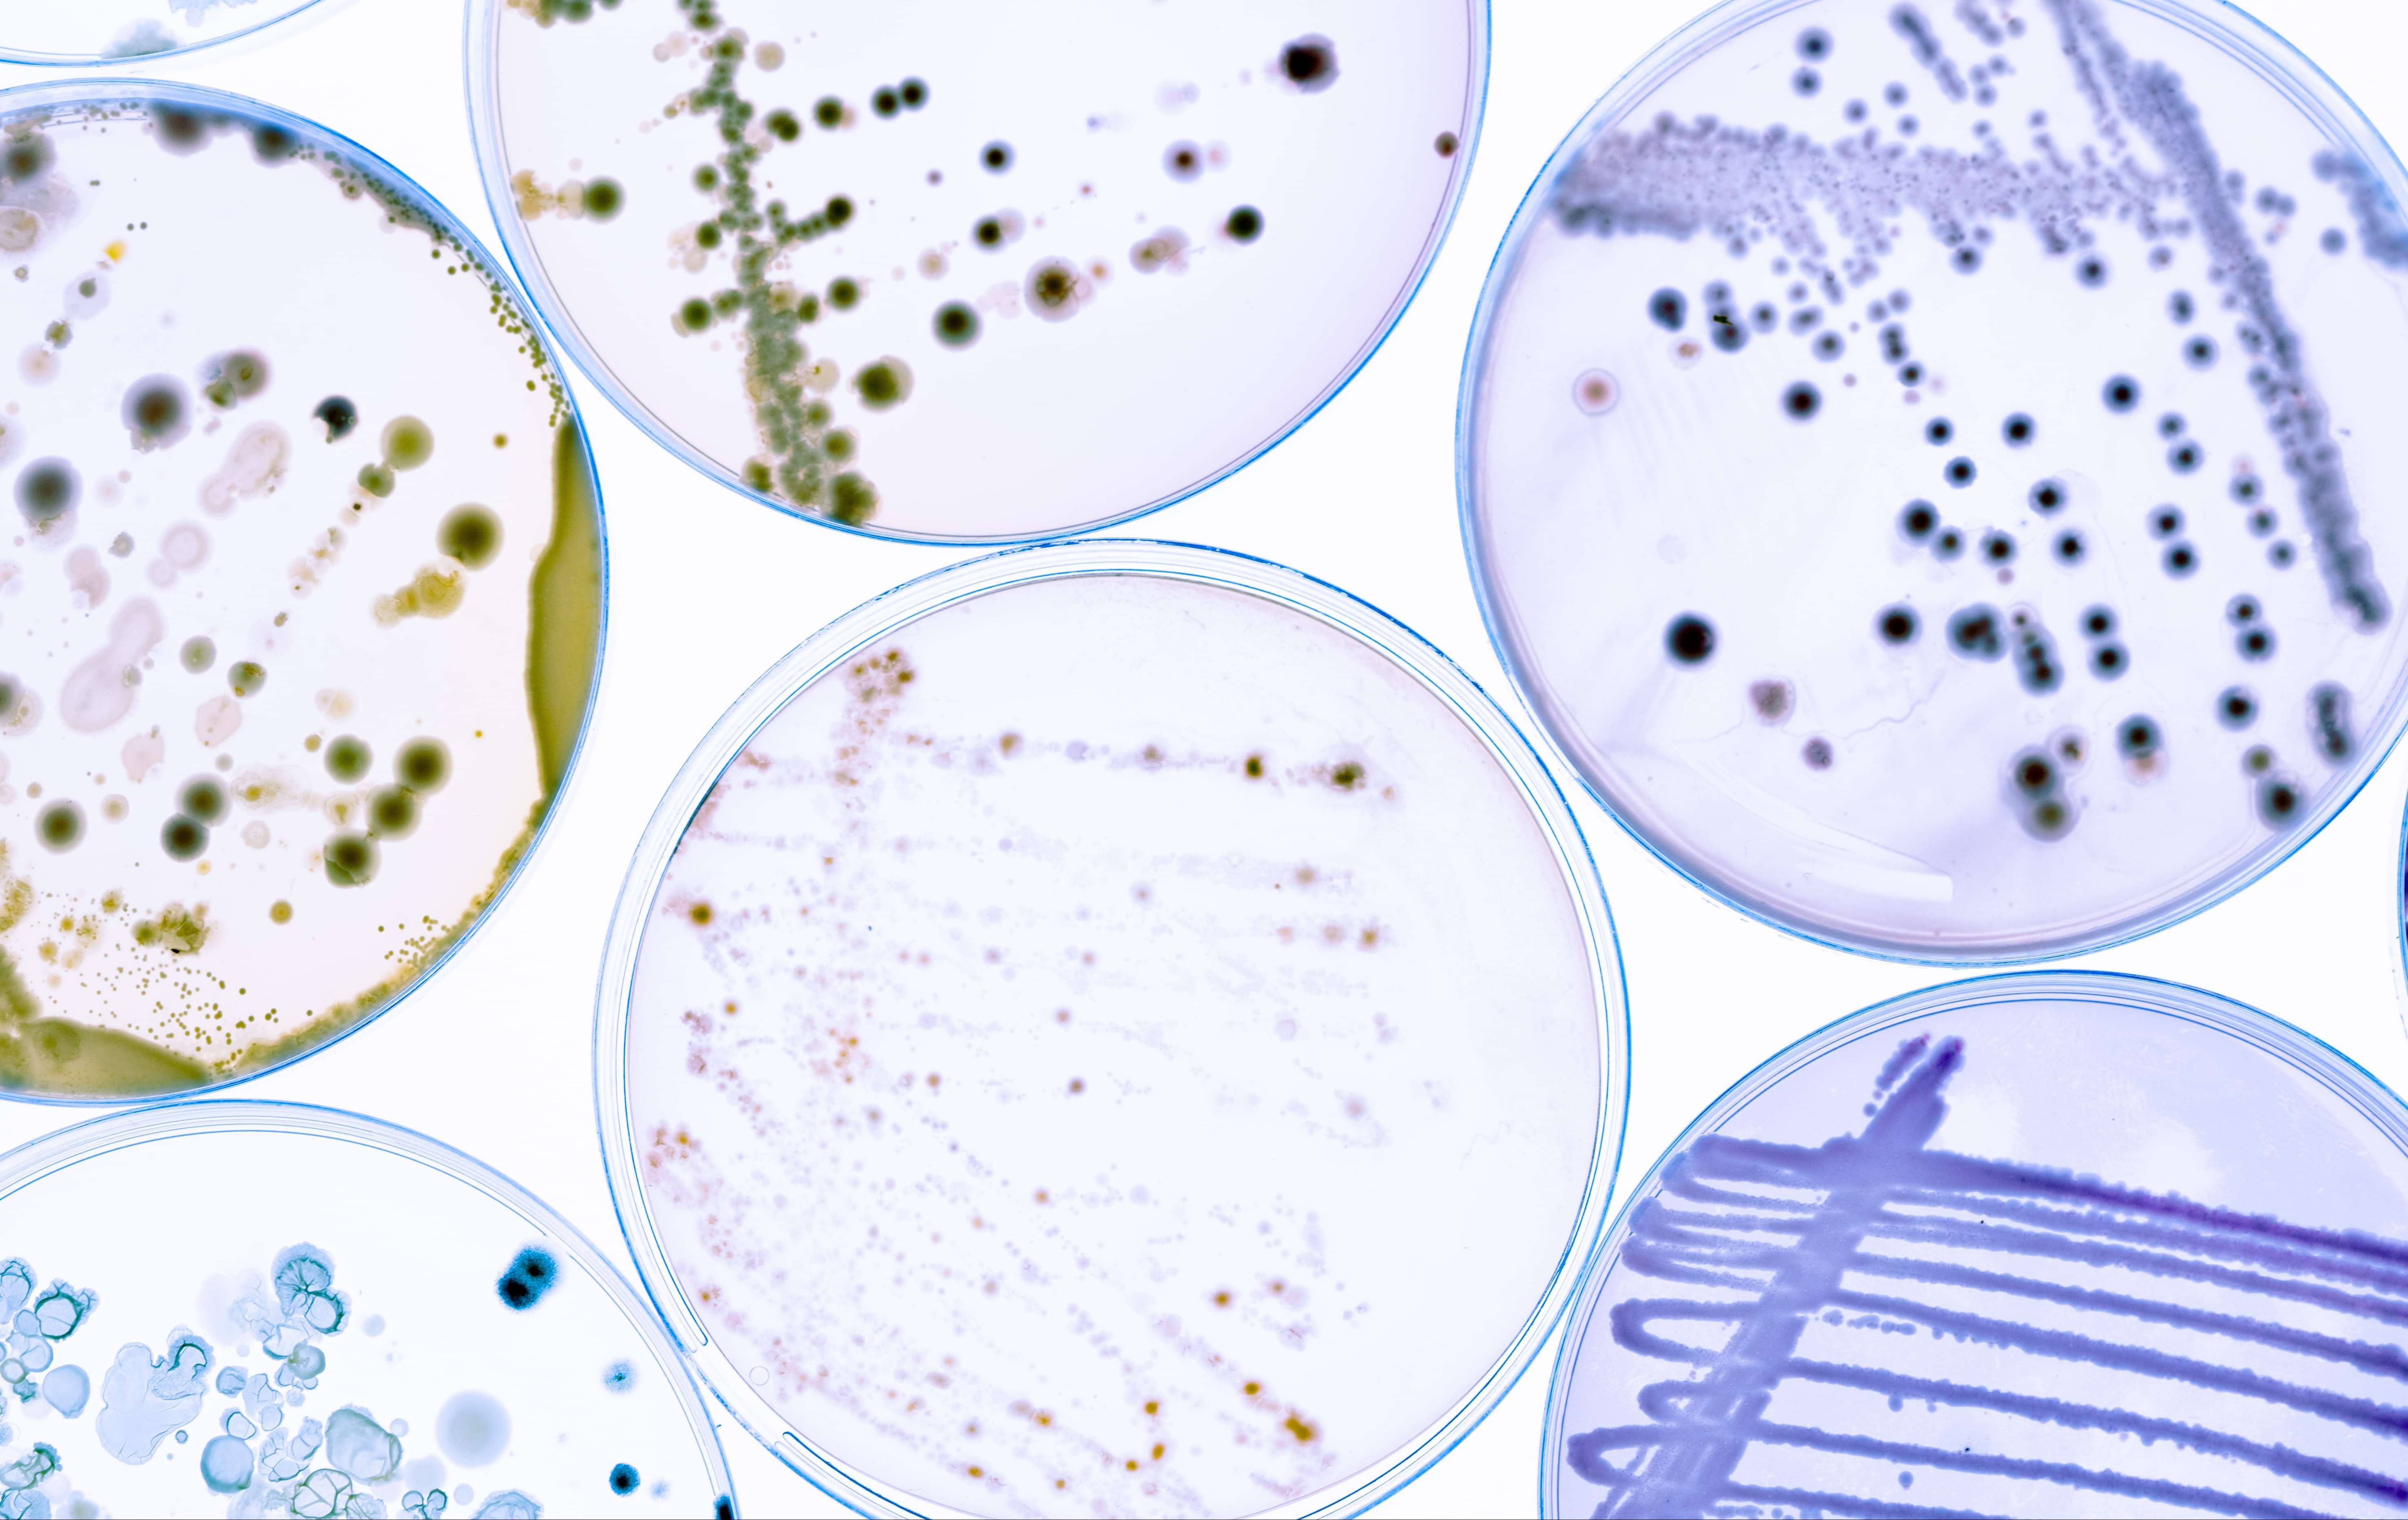
发酵检测.jpg

MicroWell
微室芯片
适配DonutFlick全景单细胞分选仪,芯片中包含有序排列的微室结构,每个微单元都可以独立捕获细胞,分选过程中,激光与芯片上的薄膜介质相互作用,产生推力将细胞轻柔地从空中分离到上层流动层,在保持细胞活性的同时将其分选至96孔板中。
产品优势
-
单细胞分选培养成活率>90%
结合激光诱导向前转移(LIFT)与光束整形技术,单细胞得率超过95%。针对动物细胞,单细胞分选培养成功率均达到90%以上。
-
原位孵育,实时观测
芯片上样后,可放回培养箱中进行长时间孵育,并随时观察细胞在各孔中的状态,满足细胞动态研究。
-
满足各种细胞分选需求
适用于各种样品类型以及不同种类细胞的分选实验,对于低生物量、稀有细胞样品也同样适用。
产品应用
-
 单克隆培养
单克隆培养可基于荧光信号,对细胞进行靶向性筛选培养,提高稳转细胞株构建效率。
-
 单细胞转录组测序(Smart-seq)
单细胞转录组测序(Smart-seq)分选后的细胞可进行基于Smart-seq的单细胞转录组测序,实现稀有细胞的精准基因分析。
-
单克隆培养
单克隆培养可基于荧光信号,对细胞进行靶向性筛选培养,提高稳转细胞株构建效率。
-
 单细胞转录组测序(Smart-seq)
单细胞转录组测序(Smart-seq)分选后的细胞可进行基于Smart-seq的单细胞转录组测序,实现稀有细胞的精准基因分析。






